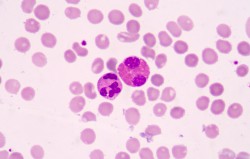

Limfomul, tumora care afectează celulele imunităţii
Deși de regulă vorbim despre tumori care afectează organe precum plămânii, colonul sau stomacul, există și o formă de cancer care pornește de la nivelul celulelor albe ale sângelui, numite limfocite. În mod normal, rolul acestora este să lupte împotriva infecțiilor, dar uneori se pot transforma în celule maligne, iar tumora poartă numele de limfom.
Printre semnele clinice ale limfomului se numără ganglioni inflamați localizați frecvent la nivelul gâtului, la subraț sau inghinal, precum și alte semne nespecifice precum febra, transpirațiile abundente pe timpul nopții, oboseala și scăderea în greutate.
Există mai multe tipuri de limfoame, iar diagnosticul de certitudine al acestora este realizat de către medicul anatomo-patolog în urma biopsiei efectuate dintr-un ganglion limfatic. Biopsia permite stabilirea tipului de limfom și stadiul acestuia. Informații necesare alegerii terapiei. Tratamentul presupune în principal chimioterapie, uneori și radioterapie sau transplant de celule stem.
Unele forme de limfoame au un prognostic foarte bun și se pot vindeca.
Este important să reținem că inflamarea ganglionilor apare în general în situații mai puțin grave, dar este necesar ca medicul nostru să excludă și afecțiunile maligne.
În diagnosticul și tratamentul limfoamelor, care sunt afecțiuni diferite de leucemii, este implicată o echipă de specialiști formată din hematolog, oncolog, radiolog și anatomo-patolog.
Nu uitați, însă, că medicul de familie vă stă la dispoziție pentru informații și este cel care vă direcționează spre acești specialiști și joacă un rol important în depistarea precoce a cancerelor.









